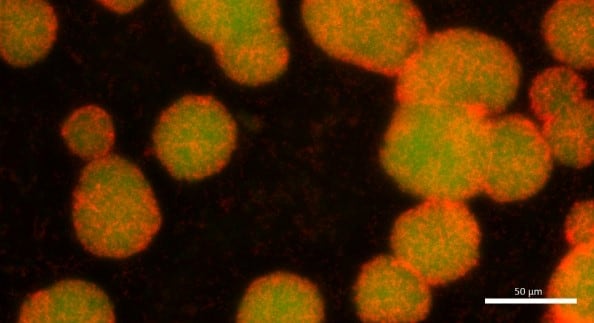

Polyols have a positive effect in oral care products. Among them, erythritol significantly impacts oral biofilm growth, even under the short exposure times that typically replicate real-life, daily oral care routines.
When we look at the threats our teeth face everyday, we mostly refer to bacteria and plaque. But what is plaque, and why is it a problem? Plaque is an agglomeration of microorganisms, usually bacteria, embedded in a matrix of polymers that convey mechanical protection to the microorganisms.1 This is sometimes considered a biofilm. Biofilms are reported to be associated with dental caries, periodontal disease and gingival conditions.2
Therefore a common goal of oral hygiene measures is to reduce the burden of biofilm in the oral cavity. The most obvious way to do so is by mechanical removal (brushing), but also by applying ingredients that impact bacterial growth. Polyols such as sorbitol, xylitol and erythritol are proven beneficial ingredients in the fight against detrimental biofilms.
The use of polyols in oral care products
Polyols are generally known to be non-cariogenic, as they cannot be metabolised by certain unwanted bacteria in the oral cavity. Thus, the growth of some bacteria, which are associated with pathogenic conditions, is reduced.3,4 While xylitol is probably the most prominent polyol used to support oral health, a number of recent studies highlight the potential of erythritol to act in the same way.5 However, the different study set-ups make it difficult to compare results and to draw adequate conclusions regarding the effect in realistic exposure scenarios.
A safe way to improve taste and oral health
ERYLITE® (Erythritol) is a white, crystalline and odourless product used in food, beverages and personal care products. It is a natural, non-cariogenic sweetener approximately 60% as sweet as sugar. It is considered natural as it occurs in nature, and the production process is based on a non-genetically modified yeast fermentation of plant based raw materials. In oral care products, ERYLITE® improves taste and offers the possibility to formulate innovative products with special cooling effect, e.g. tooth tablets or toothpaste with crystals.5 Erythritol also serves as tooth air-polishing powder, as used in professional prophylaxis by dentists. Plus, in contrast to xylitol, erythritol is safe and effective in dog oral care products.6
In March 2023, Jungbunzlauer published a study investigating the effect of ERYLITE® compared to xylitol on biofilm growth of Streptococcus mutans in an in vitro model, applying realistic exposure times of 1 and 3 minutes and concentrations of 5 and 10%. In doing so, we aimed to mimic a “tooth brushing scenario” or a “mouthwash scenario”. The effect on biofilm was determined by viable plate counting, fluorescence microscopy and a luminescence assay. All methods showed that ERYLITE®, as well as xylitol, significantly reduced biofilm growth.
Image under a fluorescence microscope after live/dead staining of biofilm samples (40x magnification). Dead cells appear red, live cells appear green.
The performance of ERYLITE® is comparable to xylitol. ERYLITE® is thus suitable for application in diverse product formats for oral health, such as mouthwash, toothpastes, gels and tablets. It is a highly valuable natural ingredient, which not only adds sweetness but also comes with a positive impact on oral biofilms.
Like all Jungbunzlauer products, ERYLITE® profits from its sustainability initiatives reduce greenhouse gas emissions. Details are available in Jungbunzlauer’s annual Sustainability Report.
References
1. P. D. Marsh, Dental plaque as a biofilm and a microbial community - implications for health and disease, BMC Oral Health 2006, 6, 1–7.
2. S. Murakami, B. L. Mealey, A. Mariotti, I. L. C. Chapple, Dental plaque-induced gingival conditions, J. Periodontol. 2018, 89, S17–S27.
3. M. l Cannon, M. Merchant, W. Kabat, L. Catherine, K. White, B. Unruh, A. Ramones, In vitro studies of xylitol and erythritol inhibition of Streptococcus mutans and Streptococcus sobrinus growth and biofilm production, J. Clin. Pediatr. Dent. 2020, 44, 307–314.
4. K. K. Mäkinen, M. Saag, K. P. Isotupa, J. Olak, R. Nõmmela, E. Söderling, P.-L. Mäkinen, Similarity of the effects of erythritol and xylitol on some risk factors of dental caries, Caries Res. 2005, 39, 207–215.
5. T. Berninger, T. Bernsmeier, ERYLITE® Erythritol in oral care, FACTS Jungbunzlauer 2019.
6. M. Shimizu, S. Miyawaki, T. Kuroda, M. Umeta, M. Kawabe, K. Watanabe, Erythritol inhibits the growth of periodontal-disease-associated bacteria isolated from canine oral cavity, Heliyon 2022, 8, e10224.